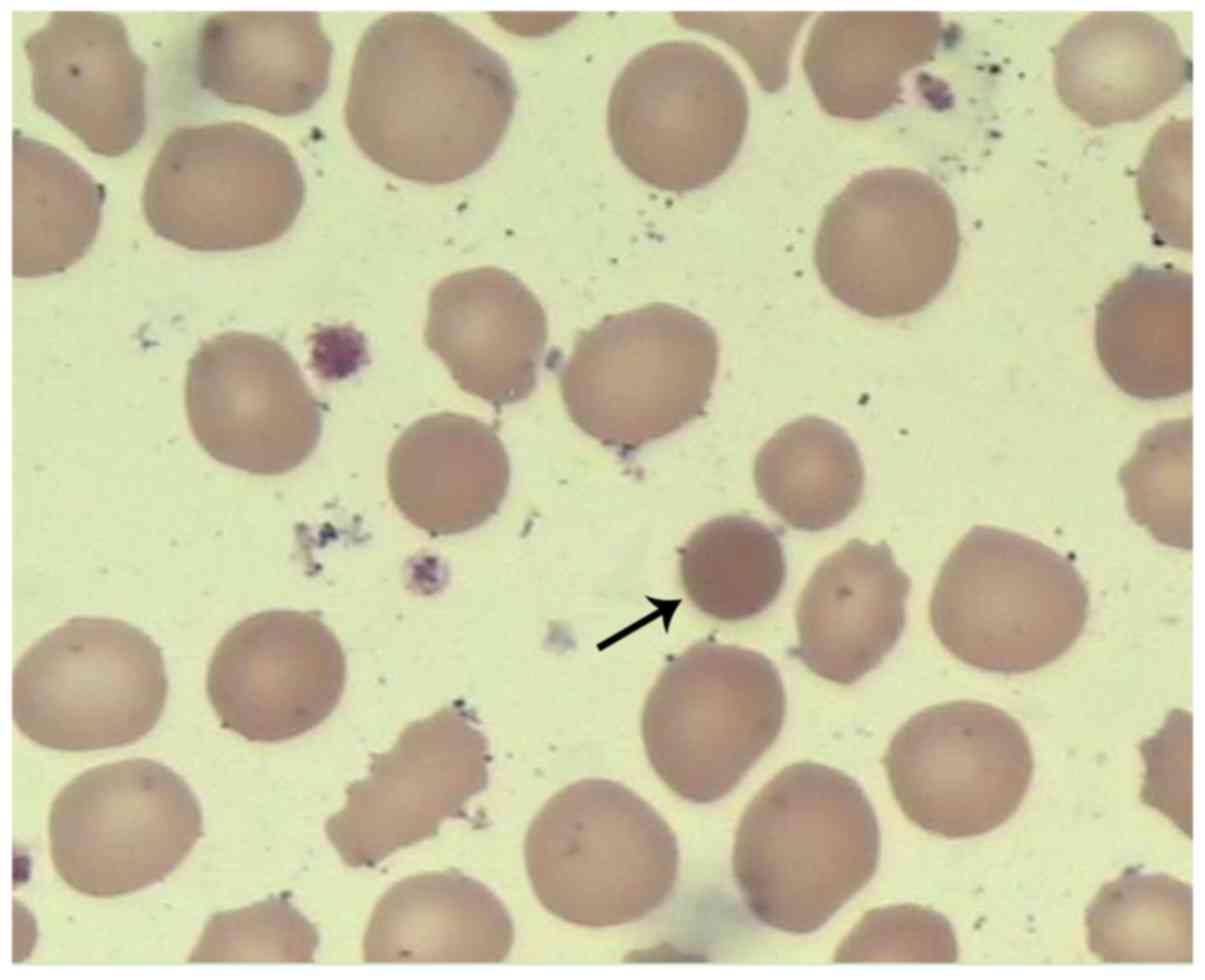

Introduction
Hereditary spherocytosis (HS), which is also known
as Minkowski-Chauffard disease, is a heterogeneous disease and a
type of non-immune hemolytic anemia that is identified by
spherocytes in the peripheral blood smear of patients. The clinical
manifestations of HS include anemia, jaundice and splenomegaly.
Most of the neonates with HS present with jaundice at the early
stages of the disease, which then progresses into severe anemia
(1). For the neonates with HS aged
<1 year, the clinical manifestations are usually severe, with
the majority of patients showing initial jaundice and subsequent
severe anemia. In contrast, in the affected neonates aged >1
year, the conditions showed gradual attenuation (2). According to previous studies (3-7),
early-stage diagnosis and treatment contribute to the reduction of
adverse events. In North Europe and North America, the prevalence
of HS in the neonates was 1/5,000 and 1/2,000, respectively
(4). In mainland China, the
prevalence of HS in male neonates (<1 year old) was indicated to
be 0.18/1 million, while the prevalence was 0.19/1 million among
female counterparts between January 1987 and December 2013(2). To date, in hospitals on a country level
or even from communities, which accounts for ~70% of the country's
medical resources, only ~3% of total number of HS cases are
diagnosed (2). The present study
reports on a neonate with HS, and summarizes the clinical
manifestations, laboratory test findings and gene sequencing data
gained. This report will contribute to the understanding and
diagnosis of the HS in neonates and expand the spectrum of
SPTB gene mutations.
Case report
A 26-day-old female neonate was admitted to Tianjin
Children's Hospital due to jaundice on February 13, 2018. The
neonate was born via spontaneous delivery at a gestational age of
41 weeks. After birth, the neonate was breast-fed and the
defecation of the neonatal meconium was normal. Jaundice was
noticed ~24 h post-delivery and phototherapy lasting for 2 days was
subsequently performed at Nanpi County Hospital, Hebei Province,
China. The condition showed slight attenuation. No obvious
remission or deterioration was noticed when the patient was
admitted to the hospital. No urine that was dark brown in color,
kaolin stools or torsion spasm were observed. The patient's father
had a history of anemia, and received cholecystectomy due to
gallstones. The patient's mother had no history of haematological
system diseases.
On physical examination, the body temperature of the
patient was 36.5˚C, the respiration rate was 50
breaths/min, the pulse was 150 beats/min and the blood pressure was
65/35 mmHg. The blood oxygen saturation level was 94%. According to
the standard of growth curves for Chinese children and adolescents
which contains weight, length/height, head circumference,
weight-for-length/height and body mass index aged 0-18 years, the
child's nutrition and development were normal (8). The results of neonatal behavioral
neurological assessment showed that the child's mental response was
satisfactory. Ochrodermia was observed across the whole body.
Estimation of bilirubin according to the location of jaundice on
the skin, the bilirubin value of the child was close to 5-10 mg/dl.
No edema was observed. The doctors in the department of neonatology
carried out physical examination on the patient and no positive
signs were indicated, such as lassitude, feeding difficulty and
hepatosplenomegaly. For the blood routine examination, the
hemoglobin level was 51 g/l (normal range, 110-160 g/l), the mean
corpuscular volume (MCV) was 81.5 fl (normal range, 86-100 fl), the
mean hemoglobin was 29.3 pg (normal range, 26-31 pg), the mean
hemoglobin concentration was 384 g/l (normal range, 210-370 fl) and
the red cell distribution width was 53.8 fl (37-50 fl). The results
of cell counting demonstrated that a total of 10 intermediate
erythroblasts and 3 acidophilic erythroblasts were identified per
100 leukocytes. These were counted manually using an Olympus CX21
optical microscope (100X oil immersion objective; Olympus Optical
Co, Ltd.). The proportion of reticulocyte was 12.3%. The number of
leukocyte was 11.03x109/l. The proportion of
lymphocytes, neutrophils, monocytes, eosinophils and basophils was
60, 31, 7, 1 and 1%, respectively. The platelet count was
333x1011/l. The concentration of C-reactive protein was
<2.5 mg/l. The results of the blood smear test indicated that
the morphology of the erythrocytes was different, the spherocyte
was smaller than the normal erythrocyte (Fig. 1), in which spherocytes accounted for
~5% in total. Hemolysis findings revealed that the proportion of
alkali-resistant hemoglobin was 47.97%, while the acidified
glycerin hemolysis test (AGLT) was 110 sec (control, 290 sec). No
aberrant changes were identified in the hemoglobin electrophoresis
and glucose-6-phosphate dehydrogenase (G-6-PD) activity. The
concentration of ferritin was 588.6 µg/l. The folic acid, vitamin
B12 and serum iron were within normal ranges (folic acid 5-6 µg/l,
vitamin B12 200-800 ng/l, serum iron 12.8-31.3 µmol/l). The
unsaturated iron and the total iron-binding capacity were 23 µmol/l
(normal range, 26-51 µmol/l,) and 50 µmol/l (normal range, 55-77
µmol/l), respectively, which were lower than the normal ranges. For
the biochemical analysis, the direct bilirubin, indirect bilirubin,
and lactate dehydrogenase was at a concentration of 11.2, 139.8 and
553 U/l, respectively. The liver and renal function was normal, and
the results of blood gas analysis and electrolyte findings were
normal. A serological test for hemolysis indicated that the patient
was of type O blood group (RHD positivity). The patient's mother
was blood type A (RHD positivity). The direct antiglobulin test,
free antibody test and antibody release test were all negative. No
abnormalities were noticed in the TORCH test. The examinations of
auto-antibodies, electrocardiogram, echocardiography and imaging
examinations of the chest and abdomen were within their normal
ranges. Ultrasonography indicated no abnormalities in the liver,
gallbladder, spleen, kidneys or brain.
Upon admission, the patient received phototherapy.
Type O washed red blood cells were supplemented to correct the
anemia, together with supporting therapy. The whole treatment
duration was four days. The jaundice showed remission, and the
anemia was corrected. Finally, the patient exhibited a satisfactory
outcome. In the 9-month follow-up, the patient received
erythrocytes supplementation due to anemia at months 3 and 7,
respectively. No jaundice, splenectasis or liver dysfunction were
observed.
Genetic analysis
The genomic DNA was extracted from the patient's and
her parents' peripheral blood using the QIAamp blood DNA mini kit
(QiagenGmbH) following the manufacturer's protocol. The exome
sequencing kit (xGen® Exome Research Panel; Integrated
DNA Technologies, Inc.) was used for the preparation of the
sequencing library. The generated library was analyzed on the
NextSeq 500 analyzer (Illumina, Inc.) for the sequencing of the
exons of the 302 genes associated with hematological system disease
related genes (such as ANK1, SPTA1, EPB42,
SLC4A1 and SPTB). The mean sequencing depth was 100X.
Sequencing data was processed using Burrows-Wheeler-Aligner forhg19
reference sequence (9) alignment and
a Genomic-Analysis-Toolkit (V4.0.6.0) for variant calling. Variants
annotation was performed using Annovar (V20180118) (10).
According to the high-throughput sequencing results,
the SPTB mutation was verified using Sanger sequencing based
on the neonatal and parental DNA samples. Specific primers were
designed using the Primer Premier 5.0 software (PREMIER Biosoft)
for the coding region of the exon of the target gene (forward,
5'-CCGCTCATGGAATCCCAC-3'; reverse, 5'-GGAGTAGTGCCTCCTCCCTG-3'). PCR
amplification was performed using the 2XPCR Master mix polymerase
(Qiagen, GmbH) on an ABI 9700 PCR facility (Thermo Fisher
Scientific, Inc.). The thermo cycling conditions of PCR were as
follows: 95˚C for 10 min, followed by 35 cycles of 95˚C for 30 sec,
60˚C for 30 sec and 72˚C for 1 min, and final extension at 72˚C for
7 min. Following DNA purification, Sanger sequencing was performed
on the ABI3500 analyzer (Thermo Fisher Scientific, Inc.), followed
by sequencing comparison with the reference sequences.
Based on the determination of the crucial splicing
signals on the exons and introns of the 302 known pathogenic genes
(such as ANK1, SPTA1, EPB42, SLC4A1 and
SPTB) for the genetic deficiency of erythrocyte, a
heterozygous pathogenic gene was identified in the SPTB
gene. A mutation of the SPTB gene, c.3737delA (p.Lys1246fs),
was identified in exon 16. Additionally, the same mutation was
identified in the patient's father (Fig.
2). The mutation was a type of frame-shift mutation, resulting
in frame-shifting from Lys1246. The mutation may lead to loss of
normal function due to termination of the coded protein. Moreover,
this mutation was not available in the HGMD database (http://www.hgmd.cf.ac.uk/ac/index.php),
ESP6500 (https://evs.gs.washington.edu/EVS/), 1000 G
(http://www.1000genomes.org/) or dbSNP
(https://www.ncbi.nlm.nih.gov/snp/?term=) database.
Overall, c.3737delA on the exon 16 of SPTB identified in the
present study was a novel pathogenic mutation. Sequencing data of
the SPTB gene in the patient and her father are presented in
Fig. 3. The patient was diagnosed
with type 2 HS, which was divided into autosomal dominant (AD)
inheritance.
Prediction of protein structure
The SWISS-MODEL homology modeling server (https://www.swissmodel.expasy.org/) was used to
predict and compare the spatial structure of the wild-type protein
and the protein encoded by the mutated genes. Meanwhile, the
effects of the SPTB gene mutation on coding protein were
justified, in order to speculate the pathogenicity of the new
protein.
Fig. 4A indicates the
results of the prediction of the tertiary structure of the SPTB
protein (817-1265) using the SWISS-MODEL software. The predicted
template was Protein Data Bank ID number 4uxv.1.A. Fig. 4B summarizes the prediction data of
the protein sequence with a mutation on residue 1246. Compared with
the tertiary structure of wild-type protein, the c.3737delA
(p.Lys1246fs) mutation resulted in premature termination of the
protein, triggering the loss of the subsequent α-spiral.
Discussion
HS, which affects many individuals worldwide,
exhibits a prevalence of 27.6 per million within the Chinese
population (2). In neonates aged
<1 year, the prevalence of HS is ~0.37/1 million with a ratio of
1:1 in male and females (2).
However, a higher trend of misdiagnosis is reported among these
patients, and some patients with moderate manifestations are not
diagnosed in clinical settings (6).
Due to this, the number of patients may be higher than expected
(11).
The pathogenesis of HS may be associated with the
deficiency of a variety of membrane proteins of the erythrocytes,
including ankyrin-1, band 3, SPTB, α-spectrin and protein
4.2, which result in the decline of the surface area of the
erythrocyte membrane in patients with HS (12). Meanwhile, the damage of erythrocytes
with poor deformation capacity in the spleen of individuals with HS
is a major cause of hemolysis (8).
According to the genetic deficiency of erythrocyte membrane
proteins, HS is divided into five types (Table I), among which type 3 and 5 are of
autosomal recessive (AR) inheritance with a lower prevalence
(3,13). In this case, the patient was
diagnosed with type 2 HS, which was divided into AD
inheritance.
 | Table ICorrelation between the gene and
phenotype of the HS. |
Table I
Correlation between the gene and
phenotype of the HS.
| Type | Gene | Gene location | Protein | Genetic type | Percentage (%) | Severity |
|---|
| Type 1,
OMIM:182900 | ANK1 (612641) | 8p11.21 | Ankyrin-1 | Autosomal
dominant | 40-50 | Mild and
moderate |
| Type 2, OMIM:
616649 | SPTB (182870) | 14q23.3 | β-spectrin | Autosomal
dominant | 15-30 | Mild and
moderate |
| Type 3, OMIM:
270970 | SPTA1 (182860) | 1q23.1 | α-spectrin | Autosomal
recessive | <5 | Severe |
| Type 4, OMIM:
612653 | SCL4A1(109270) | 17q21.31 | Band-3 | Autosomal
dominant | 20-35 | Mild and
moderate |
| Type 5, OMIM:
612690 | EPB42 (177070) | 15q15.2 | Protein 4.2 | Autosomal
recessive | <5 | Mild and
moderate |
The typical features of HS include anemia, jaundice,
splenomegaly and ceticulocytosis (2). The severity of HS is divided into
asymptomatic state, mild, moderate and severe, according to the
degree of anemia (14). The majority
of patients exhibit mild HS, and up to 20-30% present with a purely
compensated hemolysis due to the balance between reticulocyte
production and red cell destruction (15). Approximately 50% of neonates with HS
are anemia-free at post-natal week one, and rare cases exhibit
splenomegaly (16). Jaundice is the
most common manifestation for neonatal HS (3,15,17).
Neonatal jaundice usually occurs within a few post-natal days. The
hemoglobin concentration would be in the normal range, cases may
develop transient or even severe anemia within a few post-natal
weeks, due to inadequate compensation of the splenic filtration
function caused by the lack of appropriate reticulocytes (7). Most of these conditions exhibit
remission within 12 months post-partum (14). In the present study, the neonate with
HS exhibited delayed remission of jaundice and severe anemia
without kernicterus. The patient was followed up for 9 months, and
blood transfusion was required to correct the anemia.
Clinical manifestations, family history and
peripheral blood smear findings are relied upon in the diagnosis of
HS. For the blood smear, patients with HS exhibit alternations of
spherocyte proportion that are associated with the severity of
anemia, as well as presence of mushroom-shaped erythrocytes,
poikilocytosis and acanthocyte (18). According to the HS diagnosis
guidelines that are proposed by the British Committee for Standards
in Haematology (6), additional tests
are not recommended for patients with HS and with typical clinical
manifestations and laboratory findings. As the clinical
manifestations in the neonatal patients with HS are not typical,
and some patients usually present spherocytes, the diagnosis of HS
in these patients is still difficult (14). A parental history of HS has been
reported in the majority (65%) of the neonates with HS (16). Therefore, determining the parental
history of anemia and/or the family history of anemia, jaundice,
splenectomy or early-stage cholelithiasis in these neonates with
jaundice is crucial for the diagnosis of HS in clinical practice
(3). In addition, the
eosin-5-maleimide binding test, osmotic fragility test, osmotic
gradient ektacytometry, AGLT and pink test all contributed to the
diagnosis of HS in clinical practice (11,19,20). For
some patients, a genetic test is required to assist the diagnosis
(14,17). In the present study, the patient's
father exhibited anemia with a family history of cholelithiasis,
which was clinically manifested as delayed remission of jaundice
and severe anemia. Finally, diagnosis of HS was confirmed based on
laboratory findings and the results of the genetic analysis.
HS is a rare disease of genetic deficiency that
lacks appropriate treatment options. Currently, its treatment is
mainly focused on the control of its severity (2). Phototherapy, which lowers the bilirubin
in the neonatal HS, is considered to be the major treatment therapy
in the early post-partum period (16). Moreover, treatment should begin
immediately to those with a high level of bilirubin or a higher
medium than the risk zone (>75th percentile zone). Furthermore,
according to the guidelines proposed by the American Academy of
Pediatrics (3), further blood
exchange transfusion is required. In cases of signs of anemia,
blood transfusion may also be required. Since erythropoiesis is
damaging at a certain post-partum period (1-4 weeks) (16), single administration of
erythropoietin could be used, or utilized simultaneously with blood
transfusion. Folic acid supplementation should be considered for
those with moderate and severe HS in order to prevent the
complications associated with folic acid deficiency (16). Splenectomy is not recommended for ~12
months after delivery (16).
Splenectomy is effective for treating moderate and severe HS,
however, it may lead to trauma, decline of immunity, and pulmonary
hypertension that is induced by arterial and venous thrombosis
(5,14). Total splenectomy may therefore be
more effective than partial splenectomy (2,21-24).
Individual follow-up schemes should be established for children
with HS, which are based on the severity of anemia and the
monitoring of the growth and development (16). Meanwhile, care should be taken
regarding iron overload in the children who undergo persistent
blood transfusion (3).
The SPTB gene, which encodes for the β
subunit of spectrin, is a member of the spectrin gene family. It is
localized on 14q23.3 with a length of 100 kb, consisting of 35
exons, and its encoded proteins form the cytoskeletal
superstructure of the erythrocyte plasma membrane (25). Upon binding with ankyrin, spectrin
serves a crucial role in the formation and stability of the
erythrocyte membrane. The SPTB gene mutation is associated
with type II spherocytosis, hereditary elliptocytosis and hemolytic
anemia of neonates (26,27). In general, the AD pattern was
reported in 75% of patients with HS, while in the remaining 25%,
the AR pattern was exhibited, or the disease was due to denovo
mutations (5). Moreover, the
inheritance patterns of some SPTB mutations are unknown
(28). In the present study, the
patient's father carried the similar mutation of the SPTB
gene, which was not identified in the patient's mother. The
patient's father had a history of anemia and cholelithiasis.
Therefore, it was proposed that this novel mutation in SPTB
gene was of AD inheritance, Therefore, the risk of HS was
speculated to be up to 50% in the second child of this family.
In general, the common mutation types of SPTB
gene include nonsense mutations, frame-shifting mutations and
splice site mutations, which give rise to mRNA defects and
truncated β-spectrin (29). In this
case, a novel mutation of c.3737delA (p.Lys1246fs) in the
SPTB gene was identified as a frameshift mutation, which led
to premature termination of the protein and the loss of the
subsequent α-spiral. Similarly, the identified mutation, expected
to encode for a truncated protein, was usually the pathogenic one
(5,30,31). In
addition, the mutation types in other populations was reviewed
(Table II). It was concluded that
the most common mutation types are nonsense and frame-shifting
mutations. This provides a direction for further exploration of the
instability and degradation of mRNA with premature termination
codons.
 | Table IIFrequency of mutation types in SPTB
gene in different populations. |
Table II
Frequency of mutation types in SPTB
gene in different populations.
| Mutation types
(%) | Missense | Nonsense | Frame shift | Splicing
mutation | Other types | No. of
mutations | (Refs.) |
|---|
| Netherlands | 21.4 | 42.9 | 14.3 | - | 21.4 | 14 | (28) |
| Korea | 9.1 | 36.4 | 54.5 | - | - | 11 | (33) |
| Chinese
Mainland | 11.8 | 47.1 | 23.5 | 17.6 | - | 17 | (34) |
| Chinese
Mainland | 33.3 | 33.3 | - | 33.3 | - | 3 | (35) |
| Chinese
Mainland | 18.75 | 50.0 | 18.75 | 12.5 | - | 16 | (36) |
The homology modeling technique is a mature
technique that is commonly utilized in structural biology, and can
notably reduce the differences between the predicted and actual
protein sequences (32). The
SWISS-MODEL software is the first homology modeling server of
protein that is completely automatized to date (30). In the present study, The SWISS-MODEL
software was utilized for the analysis of the spatial structure of
the protein sequence encoded by SPTB gene. Compared with the
predicted tertiary structure of the wild type protein, the α-spiral
was no longer available, due to premature termination of protein
transcription induced by the c.3737delA (p.Lys1246fs) mutation.
Such spatial alteration of the protein may finally result in
functional changes of β-spectrin in the erythrocyte membrane, which
then can induce the onset of the disease.
In the present study, a novel mutation of
SPTB is reported. The SWISS-MODEL software was used to
analyze the spatial structure of the protein encoded by the
SPTB gene, without validating it using laboratory data,
which will be focused on in future studies. During the follow-up,
genetic communication and suggestions were given to the parents of
the patients, together with informing the guidelines about giving
birth to a new child, in order to reduce the prevalence of HS. In
summary, the clinical manifestations, laboratory findings and gene
sequencing results of one neonatal HS case was reported in the
current study. Furthermore, the epidemiological features, clinical
manifestations, diagnosis and treatment of HS were summarized. In
cases of neonates with severe hyperbilirubinemia, special attention
should be paid to the family history, erythrocyte index and
findings of the peripheral blood smear test. For the
icterohemolytic neonates, the bilirubin should be monitored
strictly, together with appropriate treatment. Particularly, the
hemoglobin must be monitored in the post-partum period between1
week to 1 month. Gene sequencing also contributes to the diagnosis
of this disease. The identified c.3737delA (p.Lys1246fs) mutation
results in loss of α-spiral, after prediction of the tertiary
structure of protein. This may lead to the dysfunction of
β-spectrin in the erythrocyte membrane, triggering corresponding
changes in the clinical and laboratory test findings. Early
diagnosis and treatment may decrease the severity and poor outcome
among patients with HS.
Acknowledgements
Not applicable.
Funding
The present study was supported by the Program of
Tianjin Science and Technology Plan (grant no. 18ZXDBSY00170), and
the Tianjin Health Bureau Science and Technology (grant no.
2014KZ031).
Availability of data and materials
The datasets used and/or analyzed during the current
study are available from the corresponding author on reasonable
request.
Authors' contributions
YL and JZ collected and analyzed the data, and wrote
the manuscript. LS, CS and NL collected the clinical data. JS and
YF predicted the protein structure. GL and JS participated in
making substantial contributions to the conception and design,
drafting and revising the important intellectual content of
manuscript All authors read and approved the final manuscript.
Ethics approval and consent to
participate
The study protocols were approved by the Ethical
Committee of Tianjin Medical University General Hospital.
Patient consent for publication
Consent for publication was obtained from the
patient's family.
Competing interests
The authors declare that they have no competing
interests.
References
|
1
|
Tole S, Dhir P, Pugi J, Drury LJ, Butchart
S, Fantauzzi M, Langer JC, Baker JM, Blanchette VS, Kirby-Allen M
and Carcao MD: Genotype-phenotype correlation in children with
hereditary spherocytosis. Br J Haematol: May 20, 2020 (Epub ahead
of print).
|
|
2
|
Wang C, Cui Y, Li Y, Liu X and Han J: A
systematic review of hereditary spherocytosis reported in Chinese
biomedical journals from 1978 to 2013 and estimation of the
prevalence of the disease using a disease model. Intractable Rare
Dis Res. 4:76–81. 2015.PubMed/NCBI View Article : Google Scholar
|
|
3
|
Suzuki H, Kiryluk K, Novak J, Moldoveanu
Z, Herr AB, Renfrow MB, Wyatt RJ, Scolari F, Mestecky J, Gharavi AG
and Julian BA: The pathophysiology of IgA nephropathy. J Am Soc
Nephrol. 22:1795–1803. 2011.PubMed/NCBI View Article : Google Scholar
|
|
4
|
Da Costa L, Suner L, Galimand J, Bonnel A,
Pascreau T, Couque N, Fenneteau O and Mohandas N: Society of
Hematology and Pediatric Immunology (SHIP) group; French Society of
Hematology (SFH). Diagnostic tool for red blood cell membrane
disorders: Assessment of a new generation ektacytometer. Blood
Cells Mol Dis. 56:9–22. 2016.PubMed/NCBI View Article : Google Scholar
|
|
5
|
Perrotta S, Gallagher PG and Mohandas N:
Hereditary spherocytosis. Lancet. 372:1411–1426. 2008.PubMed/NCBI View Article : Google Scholar
|
|
6
|
Bolton-Maggs PH, Langer JC, Iolascon A,
Tittensor P and King MJ: General Haematology Task Force of the
British Committee for Standards in Haematology. Guidelines for the
diagnosis and management of hereditary spherocytosis-2011 update.
Br J Haematol. 156:37–49. 2012.PubMed/NCBI View Article : Google Scholar
|
|
7
|
Manciu S, Matei E and Trandafir B:
Hereditary spherocytosis-diagnosis, surgical treatment and
outcomes. A literature Review. Chirurgia (Bucur). 112:110–116.
2017.PubMed/NCBI View Article : Google Scholar
|
|
8
|
Zong XN and Li H: Construction of a new
growth references for China based on urban Chinese children:
Comparison with the WHO growth standards. PLoS One.
8(e59569)2013.PubMed/NCBI View Article : Google Scholar
|
|
9
|
Li H and Durbin R: Fast and accurate short
read alignment with Burrows-Wheeler transform. Bioinformatics.
25:1754–1760. 2009.PubMed/NCBI View Article : Google Scholar
|
|
10
|
Wang K, Li M and Hakonarson H: ANNOVAR:
Functional annotation of genetic variants from high-throughput
sequencing data. Nucleic Acids Res. 38(e164)2010.PubMed/NCBI View Article : Google Scholar
|
|
11
|
Andolfo I, Russo R, Gambale A and Iolascon
A: New insights on hereditary erythrocyte membrane defects.
Haematologica. 101:1284–1294. 2016.PubMed/NCBI View Article : Google Scholar
|
|
12
|
Farias MG: Advances in laboratory
diagnosis of hereditary spherocytosis. Clin Chem Lab Med.
55:944–948. 2017.PubMed/NCBI View Article : Google Scholar
|
|
13
|
He BJ, Liao L, Deng ZF, Tao YF, Xu YC and
Lin FQ: Molecular genetic mechanisms of hereditary spherocytosis:
Current perspectives. Acta Haematol. 139:60–66. 2018.PubMed/NCBI View Article : Google Scholar
|
|
14
|
Wang X, Liu A, Lu Y and Hu Q: Novel
compound heterozygous mutations in the SPTA1 gene, causing
hereditary spherocytosis in a neonate with Coombsnegative hemolytic
jaundice. Mol Med Rep. 19:2801–2807. 2019.PubMed/NCBI View Article : Google Scholar
|
|
15
|
King MJ, Garcon L, Hoyer JD, Iolascon A,
Picard V, Stewart G, Bianchi P, Lee SH and Zanella A: International
Council for Standardization in Haematology. ICSH guidelines for the
laboratory diagnosis of nonimmune hereditary red cell membrane
disorders. Int J Lab Hematol. 37:304–325. 2015.PubMed/NCBI View Article : Google Scholar
|
|
16
|
Christensen RD, Yaish HM and Gallagher PG:
A pediatrician's practical guide to diagnosing and treating
hereditary spherocytosis in neonates. Pediatrics. 135:1107–1114.
2015.PubMed/NCBI View Article : Google Scholar
|
|
17
|
Christensen RD, Nussenzveig RH, Yaish HM,
Henry E, Eggert LD and Agarwal AM: Causes of hemolysis in neonates
with extreme hyperbilirubinemia. J Perinatol. 34:616–619.
2014.PubMed/NCBI View Article : Google Scholar
|
|
18
|
Da Costa L, Galimand J, Fenneteau O and
Mohandas N: Hereditary spherocytosis, elliptocytosis, and other red
cell membrane disorders. Blood Rev. 27:167–178. 2013.PubMed/NCBI View Article : Google Scholar
|
|
19
|
Llaudet-Planas E, Vives-Corrons JL,
Rizzuto V, Gómez-Ramírez P, Sevilla Navarro J, Coll Sibina MT,
García-Bernal M, Ruiz Llobet A, Badell I, Velasco-Puyó P, et al:
Osmotic gradient ektacytometry: A valuable screening test for
hereditary spherocytosis and other red blood cell membrane
disorders. Int J Lab Hematol. 40:94–102. 2018.PubMed/NCBI View Article : Google Scholar
|
|
20
|
Park SH, Park CJ, Lee BR, Cho YU, Jang S,
Kim N, Koh KN, Im HJ, Seo JJ, Park ES, et al: Comparison study of
the eosin-5'-maleimide binding test, flow cytometric osmotic
fragility test, and cryohemolysis test in the diagnosis of
hereditary spherocytosis. Am J Clin Pathol. 142:474–484.
2014.PubMed/NCBI View Article : Google Scholar
|
|
21
|
Baloira A, Bastos M, Pousada G and
Valverde D: Pulmonary arterial hypertension associated with
hereditary spherocytosis and splenectomy in a patient with a
mutation in the BMPR2 gene. Clin Case Rep. 4:752–755.
2016.PubMed/NCBI View
Article : Google Scholar
|
|
22
|
Bader-Meunier B, Gauthier F, Archambaud F,
Cynober T, Mielot F, Dommergues JP, Warszawski J, Mohandas N and
Tchernia G: Long-term evaluation of the beneficial effect of
subtotal splenectomy for management of hereditary spherocytosis.
Blood. 97:399–403. 2001.PubMed/NCBI View Article : Google Scholar
|
|
23
|
Abdullah F, Zhang Y, Camp M, Rossberg MI,
Bathurst MA, Colombani PM, Casella JF, Nabaweesi R and Chang DC:
Splenectomy in hereditary spherocytosis: Review of 1,657 patients
and application of the pediatric quality indicators. Pediatr Blood
Cancer. 52:834–837. 2009.PubMed/NCBI View Article : Google Scholar
|
|
24
|
Guizzetti L: Total versus partial
splenectomy in pediatric hereditary spherocytosis: A systematic
review and meta-analysis. Pediatr Blood Cancer. 63:1713–1722.
2016.PubMed/NCBI View Article : Google Scholar
|
|
25
|
Fan LL, Liu JS, Huang H, Du R and Xiang R:
Whole exome sequencing identified a novel mutation (p.Ala1884Pro)
of β-spectrin in a Chinese family with hereditary spherocytosis. J
Gene Med. 21(e3073)2019.PubMed/NCBI View
Article : Google Scholar
|
|
26
|
Boguslawska DM, Heger E, Machnicka B,
Skulski M, Kuliczkowski K and Sikorski AF: A new frameshift
mutation of the β-spectrin gene associated with hereditary
spherocytosis. Ann Hematol. 96:163–165. 2017.PubMed/NCBI View Article : Google Scholar
|
|
27
|
Shin S, Jang W, Kim M, Kim Y, Park SY,
Park J and Yang YJ: Targeted next-generation sequencing identifies
a novel nonsense mutation in SPTB for hereditary spherocytosis: A
case report of a Korean family. Medicine (Baltimore).
97(e9677)2018.PubMed/NCBI View Article : Google Scholar
|
|
28
|
van Vuren A, van der Zwaag B, Huisjes R,
Lak N, Bierings M, Gerritsen E, van Beers E, Bartels M and van Wijk
R: The complexity of genotype-phenotype correlations in hereditary
spherocytosis: A Cohort of 95 Patients: Genotype-phenotype
correlation in hereditary spherocytosis. Hemasphere.
3(e276)2019.PubMed/NCBI View Article : Google Scholar
|
|
29
|
Maciag M, Plochocka D, Adamowicz-Salach A
and Burzynska B: Novel beta-spectrin mutations in hereditary
spherocytosis associated with decreased levels of mRNA. Br J
Haematol. 146:326–332. 2009.PubMed/NCBI View Article : Google Scholar
|
|
30
|
Barcellini W, Bianchi P, Fermo E,
Imperiali FG, Marcello AP, Vercellati C, Zaninoni A and Zanella A:
Hereditary red cell membrane defects: Diagnostic and clinical
aspects. Blood Transfus. 9:274–277. 2011.PubMed/NCBI View Article : Google Scholar
|
|
31
|
Iolascon A and Avvisati RA:
Genotype/phenotype correlation in hereditary spherocytosis.
Haematologica. 93:1283–1288. 2008.PubMed/NCBI View Article : Google Scholar
|
|
32
|
Waterhouse A, Bertoni M, Bienert S, Studer
G, Tauriello G, Gumienny R, Heer FT, de Beer TAP, Rempfer C,
Bordoli L, et al: SWISS-MODEL: Homology modelling of protein
structures and complexes. Nucleic Acids Res. 46:W296–W303.
2018.PubMed/NCBI View Article : Google Scholar
|
|
33
|
Park J, Jeong DC, Yoo J, Jang W, Chae H,
Kim J, Kwon A, Choi H, Lee JW, Chung NG, et al: Mutational
characteristics of ANK1 and SPTB genes in hereditary spherocytosis.
Clin Genet. 90:69–78. 2016.PubMed/NCBI View Article : Google Scholar
|
|
34
|
Wang R, Yang S, Xu M, Huang J, Liu H, Gu W
and Zhang X: Exome sequencing confirms molecular diagnoses in 38
Chinese families with hereditary spherocytosis. Sci China Life Sci.
61:947–953. 2018.PubMed/NCBI View Article : Google Scholar
|
|
35
|
Xue J, He Q, Xie X, Su A and Cao S:
Erratum to clinical utility of targeted gene enrichment and
sequencing technique in the diagnosis of adult hereditary
spherocytosis. Ann Transl Med. 7(S391)2019.PubMed/NCBI View Article : Google Scholar
|
|
36
|
Qin L, Nie Y, Zhang H, Chen L, Zhang D,
Lin Y and Ru K: Identification of new mutations in patients with
hereditary spherocytosis by next-generation sequencing. J Hum
Genet. 65:427–434. 2020.PubMed/NCBI View Article : Google Scholar
|